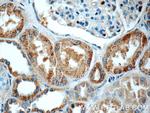
C16orf84 Antibody in Immunohistochemistry (Paraffin) (IHC (P))

Search
Proteintech
C16orf84 Polyclonal Antibody
{{$productOrderCtrl.translations['antibody.pdp.commerceCard.promotion.promotions']}}
{{$productOrderCtrl.translations['antibody.pdp.commerceCard.promotion.viewpromo']}}
{{$productOrderCtrl.translations['antibody.pdp.commerceCard.promotion.promocode']}}: {{promo.promoCode}} {{promo.promoTitle}} {{promo.promoDescription}}. {{$productOrderCtrl.translations['antibody.pdp.commerceCard.promotion.learnmore']}}
产品信息
23337-1-AP
种属反应
宿主/亚型
分类
类型
抗原
偶联物
形式
浓度
规格
纯化类型
保存液
内含物
保存条件
运输条件
产品详细信息
Immunogen sequence: QELVGSEGA YKAAVDSFLQ QQHVLGAGGG PGPTQGEEQP PQPPLDPQNL ARPPAPAQTE ALSQLFCSVR TLTAKEELLQ TLRTHLILHM ARAHGYSKVM TGDSCTRLAI KLMTNLALGR GAFLAWDTGF SDERHGDVVV VRPMRDHTLK EVAFYNRLFS VPSVFTPAVD TKAPEKASIH RLMEAFILRL QTQFPSTVST VYRTSEKLVK GPRDGPAAGD SGPRCLLCMC ALDVDAADSA TAFGAQTSSR LSQMQSPIPL TETRTPPGPC CSPGVGWAQR CGQGACRRED PQACIEEQLC YSCRVNMKDL PSLDPLPPYI LAEAQLRTQR AWGLQEIRDC LIEDSDDEAG QS (165-515 aa encoded by BC125269)
靶标信息
Cytoplasmic tRNA 2-thiolation protein 2 (CUT2), also named as C16orf84 or NCS2, is a 515 amino acid protein, which belongs to the CUT2 family. C16orf84 localizes in the cytoplasm and Plays a central role in 2-thiolation of mcm5S2U at tRNA wobble positions of tRNA(Lys), tRNA(Glu) and tRNA(Gln). C16orf84 may act by forming a heterodimer with CTU1/ATPBD3 that ligates sulfur from thio-carboxylated URM1 onto the uridine of tRNAs at wobble position.
仅用于科研。不用于诊断过程。未经明确授权不得转售。
篇参考文献 (0)
生物信息学
蛋白别名: Cytoplasmic tRNA 2-thiolation protein 2; Cytosolic thiouridylase subunit 2; cytosolic thiouridylase subunit 2 homolog; unnamed protein product
基因别名: 2310061F22Rik; C16orf84; CTU2; MFRG; NCS2; UPF0432
UniProt ID: (Human) Q2VPK5, (Mouse) Q3U308
Entrez Gene ID: (Human) 348180, (Mouse) 66965